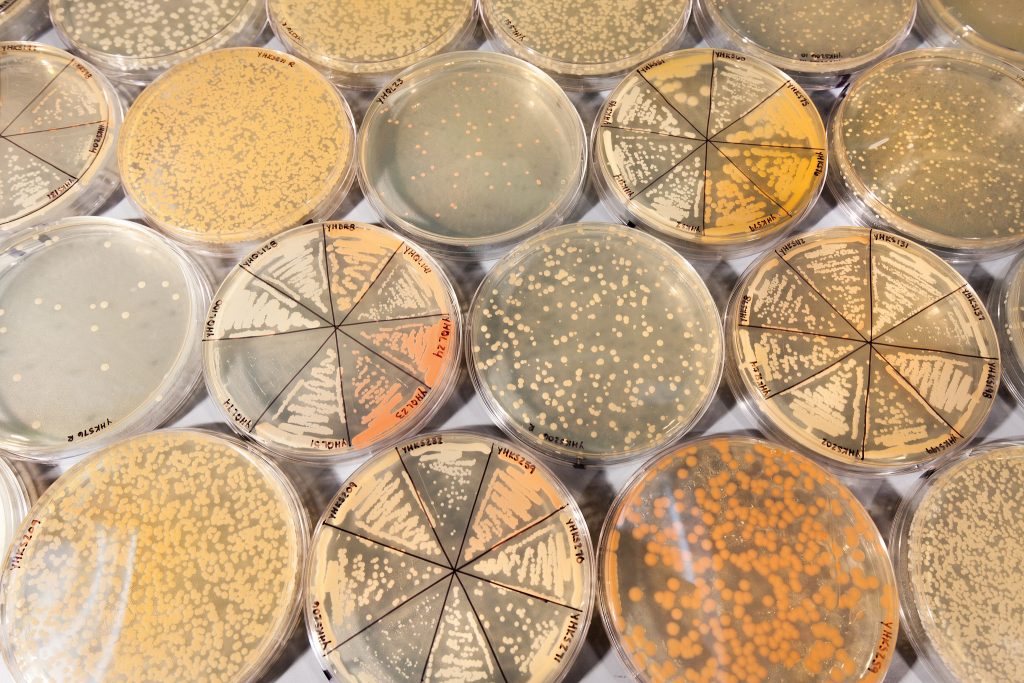

UW-Madison launches Microbiome Initiative
We are not alone. Each of us carries a wide array of microbial species that outnumber our cells tenfold. Recent studies have shown that the complement of microorganisms, the microbiome, is an important determinant of human health and disease. The microbiomes of other animals, plants, soil, bodies of water, and the atmosphere play similarly important roles.
Our understanding of the diversity and roles of these microbiomes is limited, a fact that led the White House Office of Science and Technology Policy to launch the National Microbiome Initiative last year. Stakeholders, including UW–Madison, have responded with new commitments to develop a comprehensive understanding of microbiomes across all ecosystems.
A new UW–Madison Microbiome Initiative comes with $1 million in grant funding administered by the vice chancellor for research and graduate education to support interdisciplinary research, infrastructure, and research community enhancements related to the microbiome.

“Microbiome science has the potential to revolutionize areas such as health care, agriculture, biomanufacturing, environmental management, and more,” says Marsha Mailick, UW–Madison’s vice chancellor for research and graduate education. “The potential of microbiome research is enormous — it could create revolutionary technologies. By providing seed funding for microbiome projects at UW–Madison, we hope to position our faculty to be more competitive when applying for federal funding for their research in this area.”
“Microbes influence our everyday existence in immeasurable ways. They are master chemists who have provided us with the air that we breathe. Their signatures are present in the geological record, and they are essential for many things that we take for granted from the food that we eat to the water that we drink and our health,” says Tim Donohue, UW–Madison professor of bacteriology and past president of the American Society for Microbiology.

Microbiomes maintain healthy function of these diverse ecosystems, influencing human health, climate change, food security and other factors. Dysfunctional microbiomes are associated with issues including human chronic diseases such as obesity, diabetes and asthma; global impacts such as climate change; and reductions in agricultural productivity. Many industrial processes such as biofuel production and food processing depend on healthy microbial communities.
Although new technologies have enabled exciting discoveries about the importance of microbiomes, scientists still lack the knowledge and tools to manage microbiomes in a manner that prevents dysfunction or restores healthy function.
“Advances in genomics and analytical, imaging and computational methods can be combined to understand the hidden activities of our microbial partners and how we might harness them for future environmental, agricultural, health and economic benefits,” Donohue says. “UW-Madison has the domain expertise in the biological, physical and social sciences and a rich history of collaboration. I predict this investment will build new connections from all corners of the campus and help position us as a global leader in this emerging field.”
The federal government has been investing in microbiome research for several years. More than a dozen federal departments and agencies support microbiome research today, and the magnitude of investment has recently grown: A 2015 report released by the National Science and Technology Council noted that annual federal investment into microbiome research tripled over fiscal years 2012–2014, with more than $922 million invested during this three-year period.
The goal of the National Microbiome Initiative is to generate research that elucidates general principles of microbiome behavior by finding commonalities across different habitats. UW–Madison is perfectly positioned to respond to this call because of the campus’s breadth and depth of microbiome research, Mailick says.
A large, multidisciplinary group of UW researchers across five UW–Madison schools and colleges has been focusing on microbiome research. Over the last few years, 25 UW–Madison faculty have submitted 67 research proposals to federal agencies and other funders, resulting in 20 awards that currently generate approximately $8 million annually.
“Given recent and projected investments in this area by federal agencies and private foundations, there is an opportunity for substantial growth in extramural support,” Mailick says. “That’s why we have launched the UW–Madison Microbiome Initiative.”
Funding for the UW–Madison initiative comes equally from the Chancellor’s Office and the Office of the Vice Chancellor for Research and Graduate Education.
UW-Madison faculty researchers are invited to submit proposals for research programs, infrastructure or planning activities intended to increase the breadth and depth of microbiome research on campus.
A UW–Madison committee of subject matter experts will review the proposals to identify those that hold the most promise for sustained research programs or galvanizing the community of microbiome researchers. The committee will then make recommendations to the vice chancellor’s office. The OVCRGE will make final selections.
Research and infrastructure projects will be eligible for a maximum award of $250,000. Research community enhancement awards are up to $10,000. Funding is to be spent over two years. The deadline to apply is March 15.
More information and application
This article was originally published on the UW-Madison News website.

